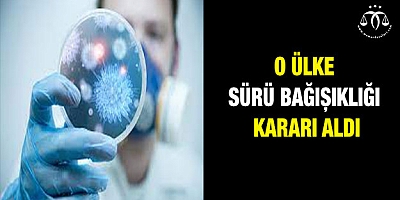
Sürü bağışıklığına gidiyor

"vaka" İLE İLGİLİ HABERLER

Tüm dünyada koronavirüs salgınıyla mücadele devam ederken, Türkiye'de uygulanan toplam doz sayısı 18 milyonu geçti. Anca..

İstanbul'da koronavirüs vakaları hızla artarken yoğun bakımlarda son durum kamerasına yansıdı. Sultangazi Haseki Eğitim..

Koronavirüs salgınıyla mücadelede önemli araçlardan biri olan HES kodunda yapılan sahtekarlıklar güvenlik riski oluşturu..

Salgının başından beri en çok merak edilen soru olan 'Koronavirüs yüzeylerden bulaşır mı?' sorusu cevap buldu. ABD Hasta..

Rekor kıran vaka ve vefat sayıları sonrası yeni tedbirlerin ele alınacağı ve bugün yapılması beklenen Bilim Kurulu topla..
Salgından en çok etkilenen ülkelerin başında gelen İngiltere, gündemi işgal eden AstraZeneca aşı krizine rağmen gerek al..

İstanbul Tıp Fakültesi Psikiyatri Anabilim Dalı’nın araştırmasına göre, Kovid-19 yalnızca tıbbi değil sosyal ve ekonomi..

Bursa'da, Kent Güvenlik Yönetim Sistemi kameralarınca maske takmadıkları ve sosyal mesafe kurallarına uymadıkları tespit..

Manisa Celal Bayar Üniversitesi Tıp Fakültesi Hastanesi sağlık çalışanlarının yürüttüğü 'SARS CoV-2 İnaktif (Sinovac-Cor..
ÇOK OKUNAN HABERLER
- BUGÜN
- BU HAFTA
- BU AY
SON YORUMLANANLAR
- HABERLER
- VİDEOLAR


 Liyakat-Sen; mesai saatleri dışında hizmet içi eğitim faaliyetlerinde görevlendi..
Liyakat-Sen; mesai saatleri dışında hizmet içi eğitim faaliyetlerinde görevlendi.. İstanbul Bilgi Üniversitesinin faaliyet izninin iptaline ilişkin karar, Resmi Ga..
İstanbul Bilgi Üniversitesinin faaliyet izninin iptaline ilişkin karar, Resmi Ga.. Aile ve Sosyal Hizmetler Bakanlığı’nın Türkiye genelinde başlattığı ‘Çocuklar Gü..
Aile ve Sosyal Hizmetler Bakanlığı’nın Türkiye genelinde başlattığı ‘Çocuklar Gü.. Gebze 4. Asliye Ceza Mahkemesi’nin 2026/235 Esas ve 2026/469 Karar sayılı dosyas..
Gebze 4. Asliye Ceza Mahkemesi’nin 2026/235 Esas ve 2026/469 Karar sayılı dosyas.. Türk Eğitim-Sen, şube ve okul müdürlerine verilen ücretsiz soruşturma görevlerin..
Türk Eğitim-Sen, şube ve okul müdürlerine verilen ücretsiz soruşturma görevlerin.. Aile ve Sosyal Hizmetler Bakanlığı tarafından ülke genelinde Sosyal Risk Haritas..
Aile ve Sosyal Hizmetler Bakanlığı tarafından ülke genelinde Sosyal Risk Haritas.. Katıldığımız bir "Güvenli Okul İklimi Toplantısı" panelinden zihnimde ağır bir t..
Katıldığımız bir "Güvenli Okul İklimi Toplantısı" panelinden zihnimde ağır bir t.. Hürriyetçi Sağlık Sen Genel Başkanı Muhammet Birinci Kocaeli - İzmit ilçe Sağlık..
Hürriyetçi Sağlık Sen Genel Başkanı Muhammet Birinci Kocaeli - İzmit ilçe Sağlık.. Türkiye Cumhuriyeti’nin kuruluş sürecinde, milletin bağımsızlık iradesini en güç..
Türkiye Cumhuriyeti’nin kuruluş sürecinde, milletin bağımsızlık iradesini en güç.. Kimisi "sadece İstanbul" dedi, kimisi "bir gün" dedi, kimisi "iki gün" dedi. Par..
Kimisi "sadece İstanbul" dedi, kimisi "bir gün" dedi, kimisi "iki gün" dedi. Par.. Milli Eğitim sisteminde disiplin soruşturmalarının yürütülmesi, hem hukuki hem d..
Milli Eğitim sisteminde disiplin soruşturmalarının yürütülmesi, hem hukuki hem d..